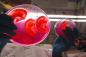

月間ランキング
- 期間:2016/06 カテゴリー総合
-
これは大人も楽しめる!シュールな絵本「はらぺこクトゥルフむし」
- 20232 points
-
ミミズクは一度信頼した人間に絶対的愛情を示す。命を救ってくれた獣医をギュッと翼で抱きしめ思慕の情を見せる(アメリカ)
- 11906 points
-
今年23歳になる息子だけどいくつになっても甘えん坊。夕食も一緒に食べるよ、巨大クマだけど(ロシア)
- 11342 points
-
娘のインスタグラムを夜な夜なチェック。その自撮りポーズの真似して比較画像を投稿し続ける父親のいる風景
- 6525 points
-
もう涙しかない!20年以上前に自分を救い出してくれた人間と再会。目に涙を浮かべ全身全霊で喜びを表すチンパンジー
- 6182 points
-
アメリカ同時多発テロ事件で大活躍した最後の救助犬が永眠。消防士たちが直立敬礼し最大限の敬意と感謝で見送る。享年16歳
- 6131 points
-
丸見えやないか!透明度がすごすぎる魚が存在した!
- 5259 points
-
キツネ?いいえ違います。シベリアンハスキーとポメラニアンの交配種、ポンスキー。
- 5231 points
-
6つの図で学ぶ「内向的な人の頭の中ってどうなってるの?」
- 4870 points
-
てんかんに苦しむ犬の守護天使となった保護猫。常に寄り添い発作を察知、飼い主に知らせる。
- 4627 points
-
12か月間、自宅の前で同じポーズで写真を撮り続けた老夫婦の記録
- 3715 points
-
解剖学を学ぶならセクシーな方が良い。18世紀のルネッサンス絵画調美女の人体解剖蝋人形(解剖学注意)
- 3459 points
-
元米軍衛生兵だけど、救急バッグの中身を公開するよ
- 3113 points
-
こりゃまたマッドサイエンスめいた・・・りんごの細胞から人間の耳を作り出すことに成功(カナダ研究者)※閲覧注意
- 2979 points
-
人間社会に嫌気がさし、四足歩行となり草を食べ、ヤギとしてヤギと共に生きる道を選んだ男の物語
- 2943 points
-
「実は私、人魚なの」 とかいう仕込みができるウロコつきストッキングが販売中
- 2864 points
-
山火事で甲羅を失った亀の為、4人の獣医と1人の歯科医、そして3Dデザイナーがタックを組んだ。3Dプリンターで見事な甲羅が出来上がった。
- 2475 points
-
第二次世界大戦直後から30年代くらいまで、昭和の日本の子どもたちの写真
- 2195 points
-
今日(6月20日)の満月は夏至直前。人々に狂気や幻覚を呼び起こすと占星術師が警告
- 2186 points
-
任務はコバエ捕獲。カエルの蛙田捕太郎氏の脱力座りがかわいいコバエとり器に人気沸騰
- 2035 points
-
海の犬っていうけれど、アザラシとかアシカって犬そっくりだったことがわかる比較画像
- 1956 points
-
庭にシマリスがやってきた。飼い猫が興味深々で近づいていったところ思わぬ展開が待ち受けていた!
- 1868 points
-
毎日のようにガレージに侵入し、犬をギュっと抱きしめて速攻帰っていく少年。彼にはこんな事情があった。
- 1792 points
-
猫が人のやさしさに触れた時、そのやさしさは伝搬する。捨て猫を拾ったらその捨て猫が捨て猫を拾ってきた物語
- 1771 points
-
逆に驚くよ。「日本の驚くべきサムライ社会」として海外に伝わっている内容がいろいろヤバイ
- 1758 points
-
今日は子供の日。入院して外に出られない子供たちの為アルバニア警察と特殊部隊がスーパーヒーローとなってただいま参上!
- 1704 points
-
SFの世界そのまんまやないか!旧ソ連の極秘放電実験施設「テスラタワー」をドローンで空撮
- 1471 points
-
まるで深い海のよう!ディープな青のワイン「Gik」の海外販売が開始される
- 1338 points
-
盗んだナイフで走り出す?国家権力に抗うカラス、事件現場に残されたナイフをくわえて逃げるという暴挙
- 1301 points
-
魅惑の淡水魚。ベタや金魚たちの流れるような美しさを引き出した写真
- 1276 points
-
ほのぼのだったり納得だったり。面白おかしい子どもたちが泣く理由
- 1228 points
-
なんていい子たち・・・メンフクロウのヒナたちはお腹がすいた兄弟に餌をゆずることが判明(スイス研究)
- 1226 points
-
その筋肉と体つきはまさに超人ハルク。イランのハルクとの異名を持つ男
- 1216 points
-
正気かよ!高さ305m、高層ビルの側面に全面ガラス張りの滑り台が設置される。
- 1177 points
-
自ら包丁を持ち刺身となった魚フィギュア「マグロ先輩」が予約販売中
- 1162 points
-
子ギツネコンコンとかかわいすぎるんじゃ~っ!ってなる画像特集
- 1134 points
-
父と娘の絆はそのボワフサな髪の毛。同じヘアスタイルでツーショット
- 1129 points
-
銭婆と黒柳徹子をコラボさせてみた。焼かずにできる、千と千尋の神隠し「銭婆ケーキ」の作り方【ネトメシ】
- 1035 points
-
グリーン系レンズのサングラスが片頭痛を緩和してくれることが判明(米研究)
- 1022 points
-
私が癒してしんぜよう。ストレスフルな学生たちを癒しに自らやってくる超なつっこいご近所猫(ドイツ)
- 1004 points
-
この世にいる全ての人は君である。火星の人、アンディ・ウィアーの短編小説「卵」のユニークな生死観で心ふわっと軽くなる
- 989 points
-
古代ギリシャ・ローマ時代のカルト信者が使用していた謎めいた手の彫刻「サバジオスの手」
- 985 points
-
どうしてもハシビロコウケーキが食べたいんじゃ!という人の為のお手軽黒ゴマハシビロコウ先輩の作り方【ネトメシ】
- 977 points
-
感動の音楽を聞くと鳥肌が立つ人と立たない人がいる。一体なぜ?そのメカニズムを解明(米研究)
- 949 points
-
美術解剖学の先生のチョークスキルがあまりにも高かった。黒板にチョークで描いた人体解剖図がハイクオリティ
- 926 points
-
なんという神秘的美しさ。だが人をも殺す猛毒を持つカツオノエボシの妖艶さを接写撮影した写真
- 897 points
-
「生まれ変わり」は本当にあるのか?前世の記憶を持つ6人の子供たちのケーススタディ
- 867 points
-
道路でひかれ横たわっていた猫を目撃したトラックの運転手、このまま立ち去るには忍びないと戻ってみたところ・・・
- 795 points
-
キューブリックの名作「シャイニング」を360度視点でみられるYOUTUBE動画
- 794 points
-
新種?いいえ違います。カレーの入った容器に落ちてカレー色に染まってしまったカモメ(イギリス)
- 792 points
206/308